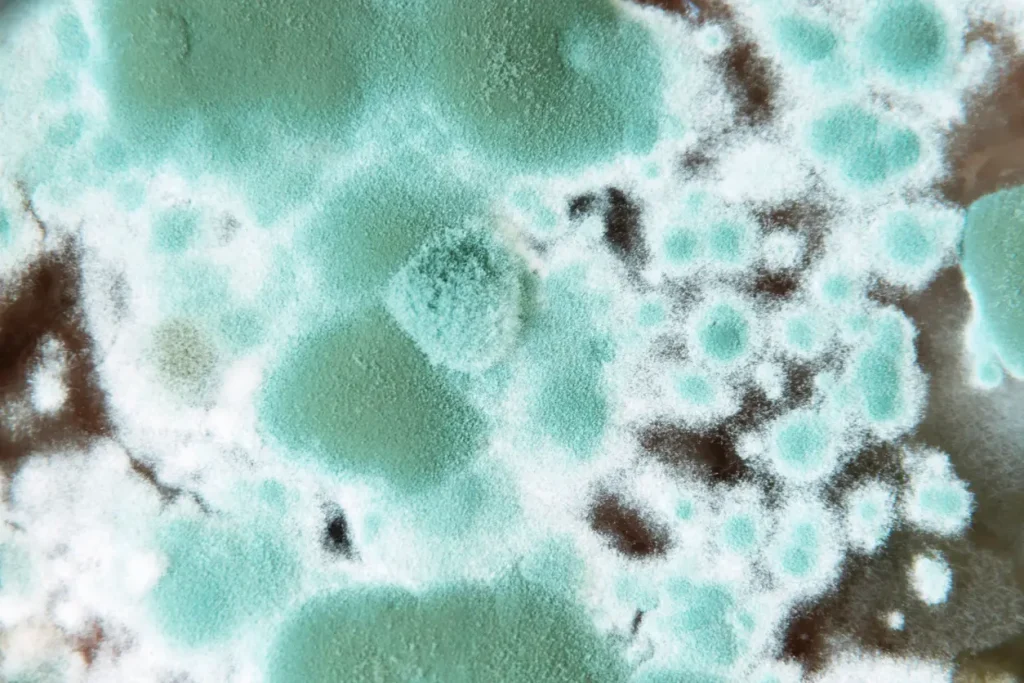

If you’re in perimenopause or menopause and suddenly feel like your body has turned on you—brain fog, fatigue, anxiety, joint pain, migraines, weight changes, sleep issues—you’re not imagining it. And it’s not “just aging.”
Hormones absolutely matter during this transition. But for some women, they aren’t the whole story.
For many of us, menopause becomes the perfect storm that unmasks an underlying inflammatory condition—most commonly mold-related illness.
I know this both professionally and personally.
During my own perimenopausal years, I experienced my worst mold exposure. At the time, it was incredibly hard to separate what was “normal hormone chaos” from what was something deeper. The symptoms overlapped almost perfectly—and that overlap delayed clarity and answers.
Why Menopause Changes Everything
Menopause isn’t just a decline in estrogen and progesterone. It’s a major shift in immune function, neurologic signaling, detoxification, and inflammatory resilience.
Estrogen plays protective roles in:
- Immune regulation
- Mast cell stabilization
- mitochondrial and brain function
- Liver detoxification and bile flow
As estrogen fluctuates in perimenopause—and ultimately declines—the body becomes far more vulnerable to inflammatory stressors. Environmental toxins like mold, which may have been tolerated earlier in life, suddenly become overwhelming.
When Mold Illness and Menopause Look the Same
One reason mold illness is so often missed during midlife is simple: the symptoms look identical to menopause.
Fatigue. Brain fog. Anxiety. Sleep disruption. Hot flashes. Joint and muscle pain. New chemical or food sensitivities.
In my own experience, the brain fog was the biggest red flag—because it felt wildly out of proportion. I had always relied on a sharp, organized mind. Suddenly I felt scattered, overwhelmed, forgetful, and unable to retain new information. I also experienced migraine, insomnia and profound anxiety. It didn’t respond the way typical hormone support should.
At the same time, I developed unexplained neck and hip pain that was surprisingly debilitating—and difficult to attribute to anything structural and did not respond to chiropractic, acupuncture or massage.
Looking back, the overlap between mold illness and perimenopause made it incredibly easy to miss what was really happening.
Estrogen, Mast Cells, and Mold
Mold-related illness often drives mast cell activation in individuals with CIRS. Estrogen fluctuations during menopause can further increase mast cell reactivity.
Add mold toxins—potent mast cell triggers—and the result can be:
- Histamine intolerance
- Flushing
- Anxiety or panic
- Migraines
- GI symptoms
- Poor sleep
This is why many women develop “new” histamine or inflammatory symptoms during midlife that don’t quite fit the standard menopause narrative.
Detoxification Slows During Menopause
Menopause can also impact liver detoxification and bile flow. When detox pathways slow, mycotoxins are more likely to recirculate rather than exit the body—amplifying inflammation, neurologic symptoms, and hormonal disruption.
This is not a personal failure. It’s physiology.
Why Hormone Therapy Alone Isn’t Always Enough
Hormone therapy can be incredibly helpful—and for many women, it’s a critical piece of the puzzle.
But mold toxins also affect the hypothalamus, which plays a central role in hormone signaling and regulation. Mycotoxin exposure can suppress hormone production, while menopause naturally lowers sex hormone levels as well.
If mold illness is present, inflammation and mast cell activation can continue underneath—even with well-prescribed hormone support.
In those cases, hormones alone won’t fully resolve symptoms. Both the internal terrain and the environmental load need to be addressed.
When to Consider Mold as a Missing Piece

I start thinking about mold illness when:
- Symptoms worsen or accelerate during perimenopause or menopause
- There’s a history of living or working in water-damaged buildings
- Multiple therapies or functional approaches haven’t brought lasting relief
- Symptoms feel “too severe” to be explained by hormones alone
Unfortunately, women in midlife are often told their symptoms are simply part of aging. Too often, they’re dismissed rather than deeply evaluated.
That’s a narrative we need to change.
Healing Requires a Whole-Body Approach
Supporting women through menopause with mold illness means addressing:
- Environmental exposure
- Detoxification pathways
- Immune and mast cell balance
- Nervous system regulation
- Hormonal support
All of these pieces matter—and they work best together.
If you’re navigating menopause and something doesn’t add up, you’re not broken. And you’re not imagining it. Environmental factors like mold may be part of the picture.
At Boulder Holistic Functional Medicine in Boulder, Colorado, we help women uncover hidden root causes and create personalized, sustainable healing plans—so you can feel like yourself again. If this story resonates, I’d love to help you explore whether mold illness may be contributing to your symptoms. Click here to schedule your consultation today.







